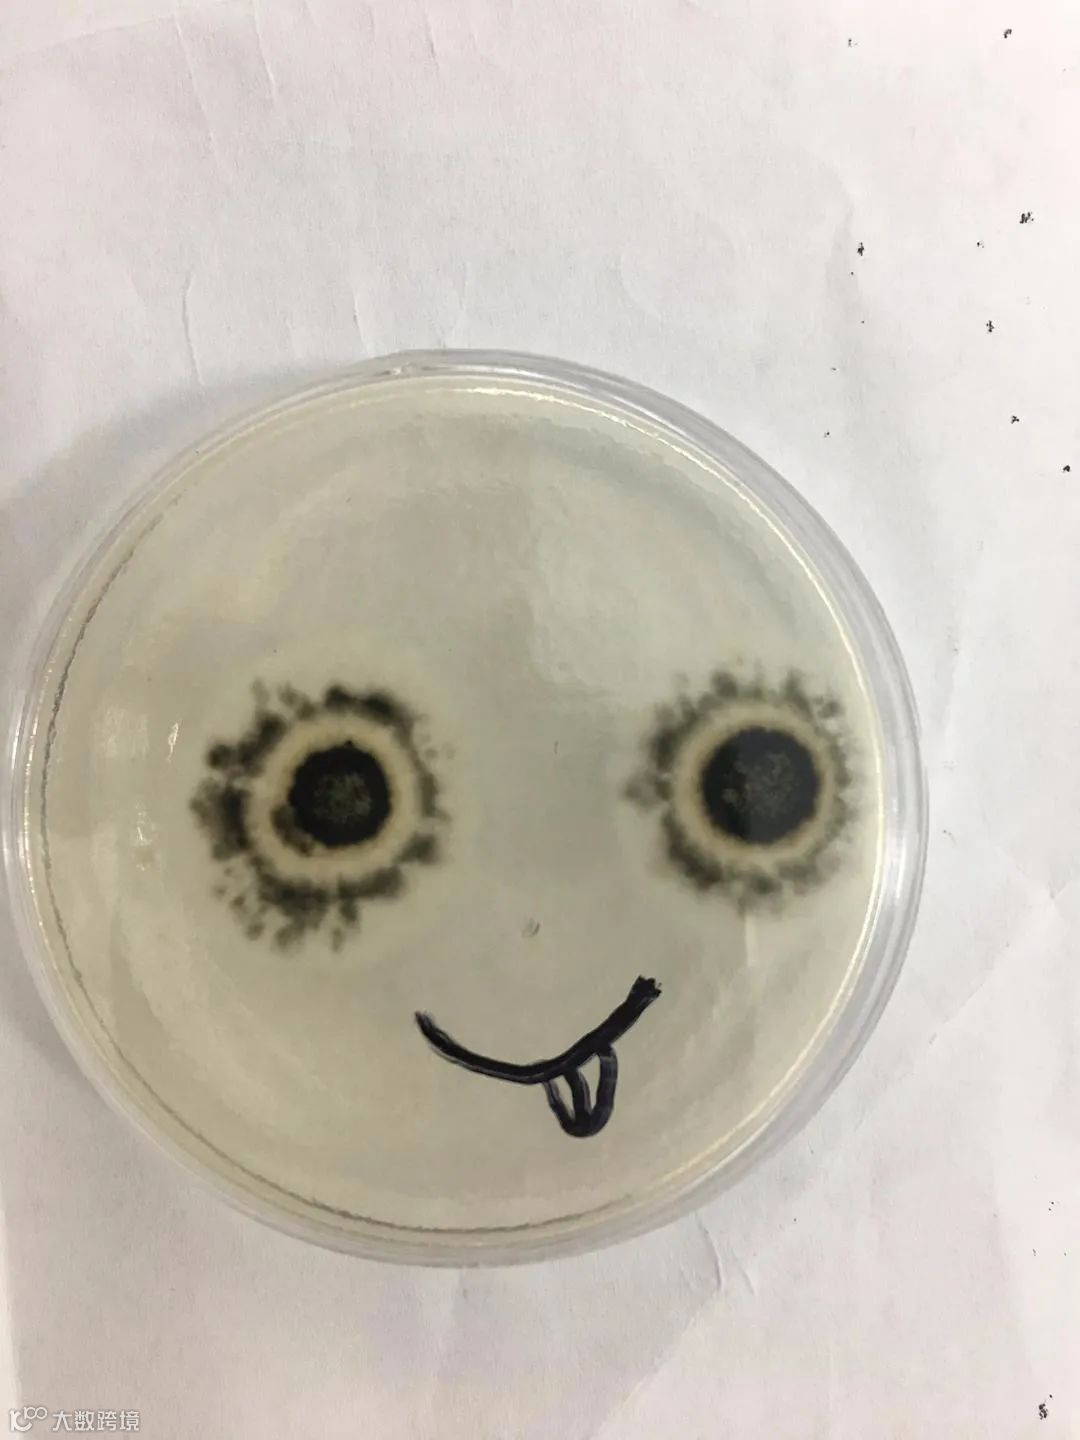
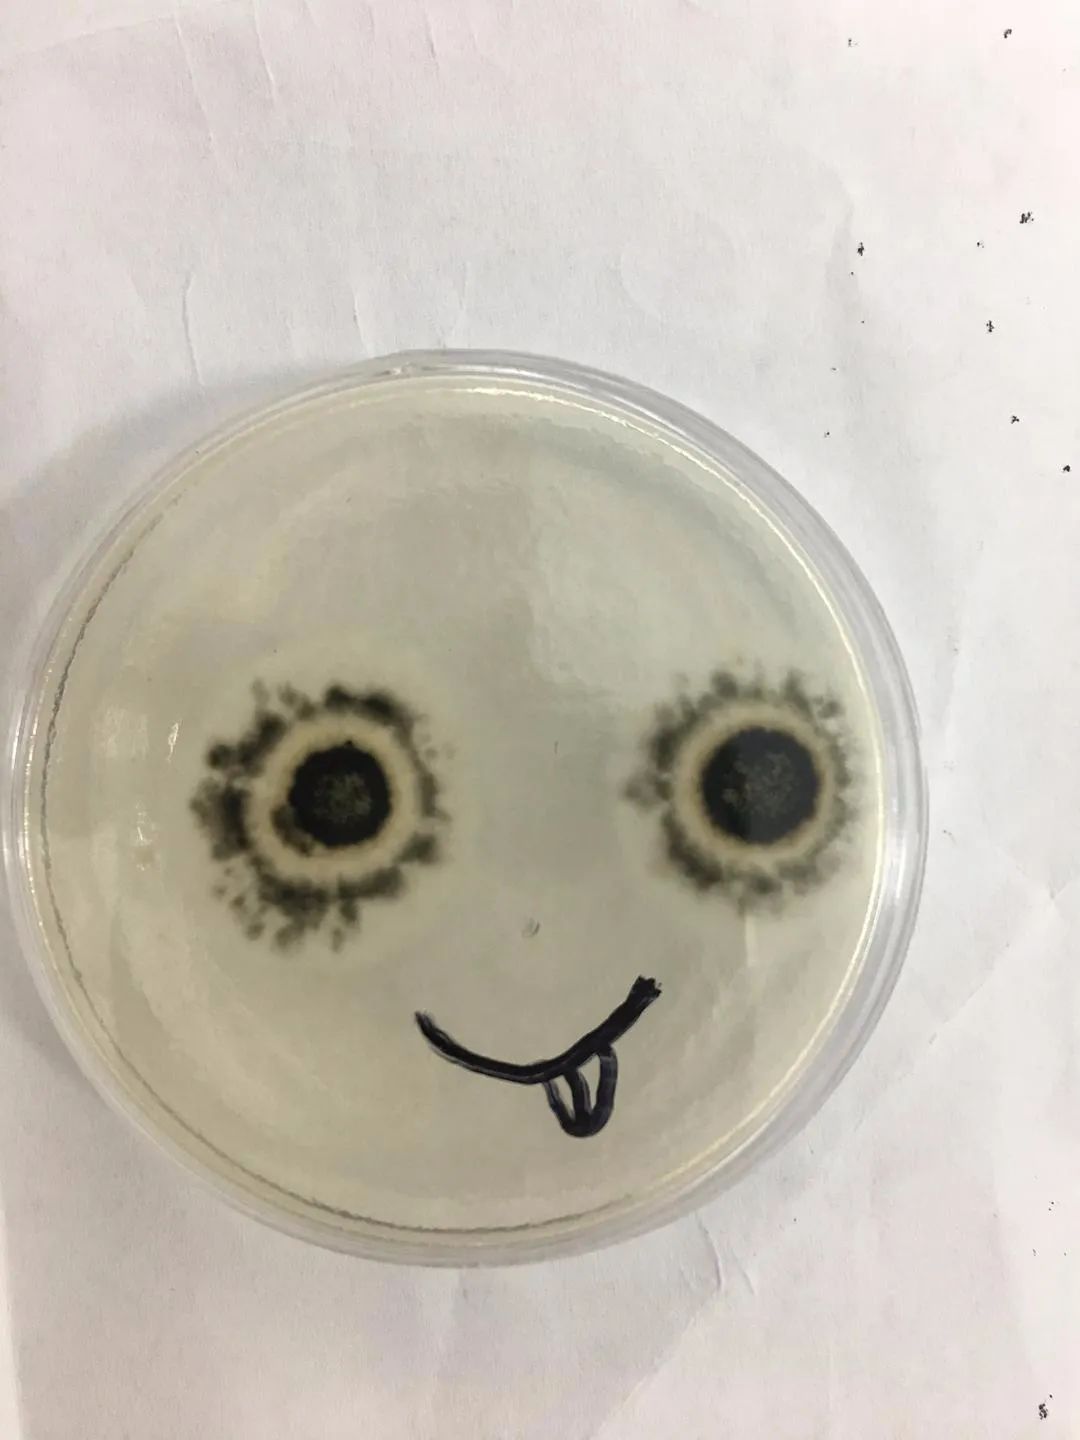

和文科常呈现出的诗词歌赋风花雪月不同,理科常常给人一种理性、严肃甚至冰冷的感觉。
其实不然,理科中所蕴含的美,非肉眼可窥。
在豆瓣话题#理科中的美学#里,我们找到了许多透过数字、显微镜、量角器才能到达的美。
还有一些专属于理科生的浪漫,我想你一定不能错过。


@狮子小白。
大学生物课上,看到显微镜下的青霉菌,当时就被惊艳到了! 手机原图,这张照片还上过豆瓣开屏 ~


@Missisissy
很多年前的高一,一束开在黑板上的花。


@裸吻鱼
昨天发了在古巴的照片,然后我爸在朋友圈这么回复了我🤷♀️🤷♀️🤷♀️ 理科直男的浪漫读不懂




@小珍珠
实验课看的石头




@在喝水的张大爷
蛋蛋里都是爱你的形状😘



@江心秋月白
培养基里无意长出的两个霉菌,我给画了一个嘴巴,自然萌。

@軟红
显微镜下的肌组织好像一个小小的星球🌖


@D白水
存了好久的 经典美学🤩🤩
《斐波那契数列:震撼心灵的几何美学》




@D白水
鲁伯特之泪
“你是我唯一的软肋。”
将熔化的玻璃靠重力自然滴入冰水中,就会形成这些蝌蚪状的“玻璃泪滴”。被俗称为“鲁珀特之泪”的这种玻璃有着奇妙的物理特性:泪珠本身比一般玻璃坚硬很多,能在8吨压力下不碎,然而,若是抓住其纤细的尾巴、稍微施加一些压力,那么整颗玻璃泪就会瞬间爆裂四溅、彻底粉碎。



@강자KONG
在网上看过一个提问:
“当我的手指划过尺子的3和4刻度之间时,我是否触摸到了π?”
抽象与具象之间界限的模糊,好美。

@ZL
日本分子生物学会杂志《Genes to Cells》长期与浮世绘画家合作,每期的封面既是一副浮世绘,也是一个生物相关的结构或现象。多年前看到时,就颇为惊艳。这些封面有的浅显易懂,而另一些,如果不解释,鬼知道是什么!似乎画家们对有丝分裂情有独钟,有好几期都是分裂的不同时期。在他们笔下,染色体,有时是风筝,有时是烟火,有时是猫……
图一:DNA双螺旋
图二:供能的线粒体
图三:分裂中期排成一排的染色体
图四:皮肤纤毛结构
图五:猫之有丝分裂
图六:DNase I 足迹法试验
图七:噬菌体
图八:信使RNA正在转录
图九:中心体产生微管










@강자KONG
人类生来就有认识无限的能力。
小学时,老师在黑板上漫不经心划了两条线,说它俩平行,我们就愿意相信它俩永远都没有交点。
可大学高等几何课,老师说,平行线相交于无穷远点,我们又相信,小时候我们深信不疑平行的两条线,此刻在无穷远点汇聚成圆。而那些在平面上相交的直线,也不是在那唯一的相会处后从此形同陌路,无穷远点处都会再重逢。
平面几何写的是我们的人生,存在的都清楚;高等几何说的是我们的灵魂,看不见的是真相。此生或无交集,也可能相遇是诀别,但我们的灵魂终将归于一处。所以不必担心,我们总会相遇,早晚而已。
在所有的概念和定义中,我最爱极限的定义。
世上怕是没有任何概念比它更准确,比它更完整,比它更简洁。
也没有概念比它更难理解。
它定义了任意,定义了存在,定义了距离,也定义了变换和关系。从此,所有看不着,摸不到的性质都有了比照。
极限好像飘渺深处,穷其一生也走不到,但我们却可以轻易脱离此刻、此身,由思想带我们的心去感受。别说话,安静,“无限接近”的动态和“但不等于”的严谨。
逻辑的,数学的。

@龙猫墨
来自数学老师的浪漫


@食堞骊
你身体里的每一个原子都来自一颗爆炸了的恒星,形成你左手的原子可能和形成你右手的原子来自不同的恒星。这是我所知的关于物理的最有诗意的事:你我都是星辰。
——物理学家 Lawrence M. Krauss

@白夜
理科生的浪漫




< END >



